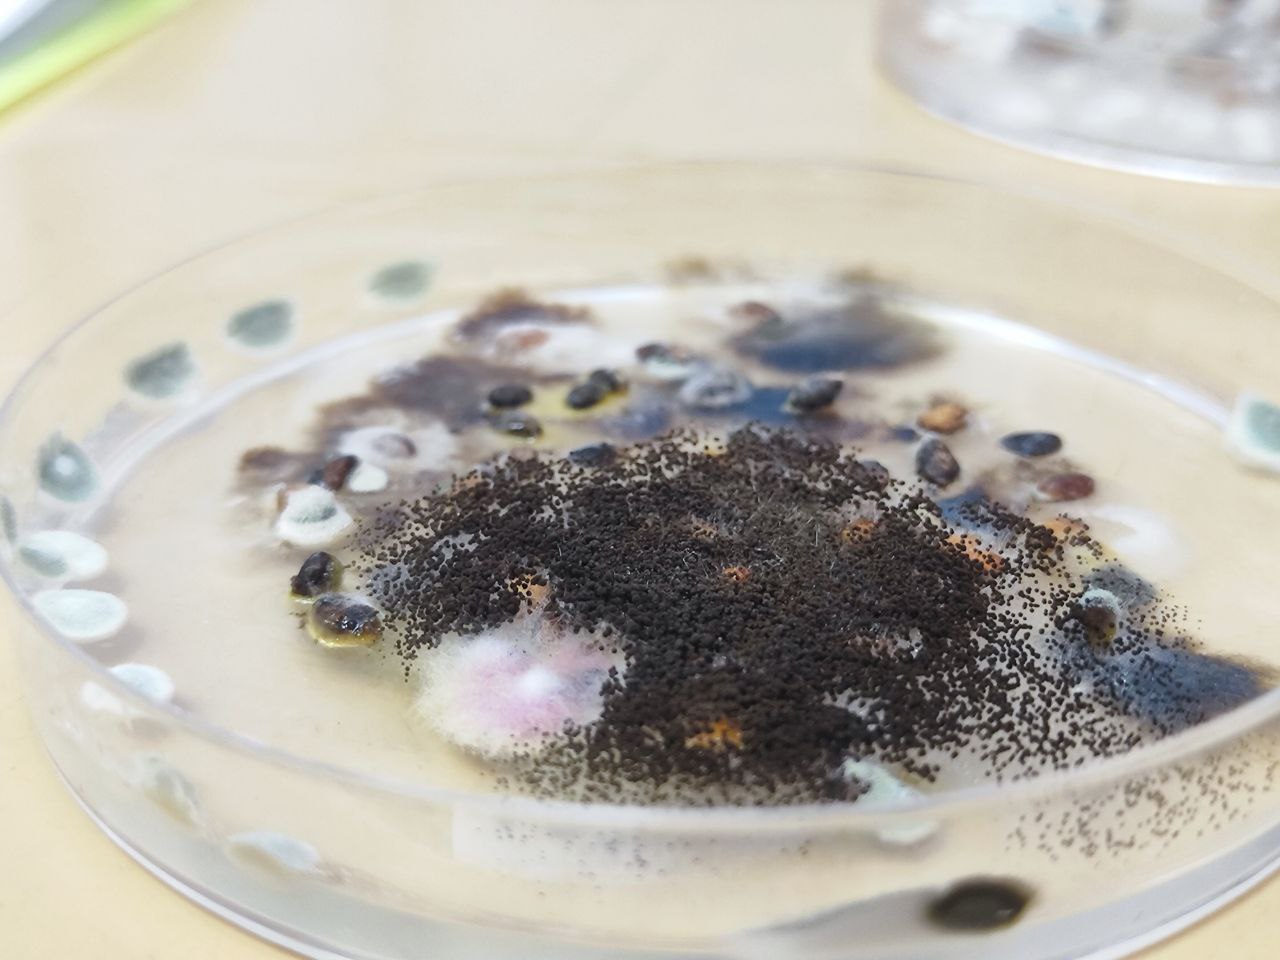

В марте 2026 года в рамках выполнения государственного задания по направлению «Государственный мониторинг воспроизводства лесов» специалистами отдела «Тверская лесосеменная станция» филиала ФБУ «Рослесозащита» - «Центр защиты леса Тверской области» проводится работа по оценке качества используемых при воспроизводстве лесов партий семян лесных растений.
Всего с начала года проверено качество 5 партий (проб) семян сосны обыкновенной текущего года заготовки, хранящихся в настоящее время на складе семян Торопецкого филиала ГБУ «ЛПЦ-Тверьлес».
Качество проверенных партий семян лесных растений общей массой 212 кг распределилось следующим образом:
- партий семян 1 класса качества нет,
- семена 2 класса качества составили 47% (100 кг),
- семена 3 класса качества – 24% (50 кг)
- и некондиционные семена – 29% (62 кг).
Патогенными грибами заражены 5 партий семян, что составляет 100% заражённость от общей массы проверенных семян.
По итогам проверки партий семян выданы документы о качестве установленной формы в соответствии с действующим законодательством. Всего было выдано 3 сертификата качества семян лесных растений и 2 результата анализа проб.
В дальнейшем работа по оценке качества семян лесных растений в рамках государственного мониторинга воспроизводства лесов будет продолжена.